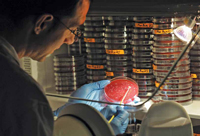
Incubation of C. difficile samples inside Whitley anaerobic workstation.

Clostridium Difficile: An Emerging Food Safety Risk
Traditionally associated with healthcare environments, C. difficile has been increasingly isolated from packaged foods and food animals, raising concerns about foodborne and zoonotic transmission to humans.
Once a relatively obscure organism to the general public, Clostridium difficile has gained recognition as a highly virulent intestinal microorganism capable of causing protracted hospital-associated diarrheal illnesses, usually in situations when antibiotics are administered (Taubes, 2008). Contributing factors to this greater awareness are a corresponding increase in the incidence of C. difficile infections (CDI), heightened severity of disease symptoms with higher reoccurrence rates, and an in…
Top
